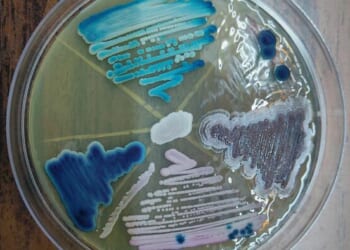
The Trump Administration's Fight To Fund Scientists

Latvia has finally finished building a long anticipated nearly 175-mile fence along its border with Russia, according to regional media on Tuesday, which cited the state-linked company responsible for managing the project.
The fence cost an equivalent of nearly $20 million, and so at that price points to it being defensively minimal and low-tech, however some additional work is still underway on supporting infrastructure – which is expected to include support items such as footbridges over marshy terrain, observation towers, and engineering installations.

The country’s Interior Minister Rihards Kozlovskis said Latvia is now deploying advanced surveillance and monitoring systems along the frontier for an eventual “modern border security system” on the European Union’s eastern edge.
This will also complement the previously erected 90-mile fence along Latvia’s border with Belarus, which has been a partner of Moscow in the Ukraine war.
A little over a year ago, Latvia had reached 80% completion of the border wall with Russia. It represents the general attitude of the Baltic neighborhood – that Russia can’t be trusted and is an ‘aggressor’ state bent on expansion.
There’s also been a rise in Baltic armies hosting war games, and exercises which are integrated with NATO, which is fast becoming a ‘new normal’.
Other countries in both eastern and northern Europe are racing to construct their own walls. For example Finland has committed $143 million to a greatly expanded fence along its southeastern boundary.
Helsinki has further announced plans for additional defensive structures, including bunkers and shelters designed to withstand direct artillery or missile attacks.
Poland too has erected electronic surveillance barrier along its border with Russia’s Kaliningrad exclave, and recent reports have said it is reintroducing land mines after long being part of an international ban on the controversial weapons.
Polish authorities have also wanted to reduce the risk of migration pressure, pointing to the launch of flights to Kaliningrad as well as Belarus from the Middle East and Africa.
Loading recommendations…